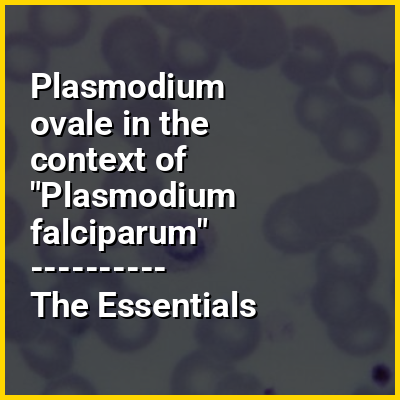

Plasmodium ovale is a species of parasitic protozoon that causes tertian malaria in humans. It is one of several species of Plasmodium parasites that infect humans, including Plasmodium falciparum and Plasmodium vivax which are responsible for most cases of malaria in the world. P. ovale is rare compared to these two parasites, and substantially less dangerous than P. falciparum.
P. ovale has recently been shown by genetic methods to consist of two species, the "classic" P. ovalecurtisi and the "variant" P. ovalewallikeri (split by Sutherland et al. 2010, names amended to binomials by Snounou et al. 2024). Depending on the type locality of the original P. ovale defined by Stephens, one of the proposed species (likely P. ovalecurtisi) may end up as a junior synonym of the old name. There is a statistically significant difference between the clinical parameters found in patients infected with either kind.